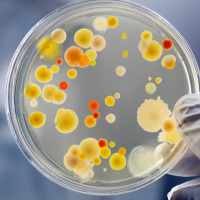

Poznaj nasze usługi
Sprawdź jak możemy Ci pomóc!

Test borelioza i wszystkie koinfekcje
Precyzyjna diagnostyka boreliozy oraz jej koinfekcji. To idealne rozwiązanie dla osób podejrzewających zakażenie po ukąszeniu kleszcza.
Więcej informacji
Test Schumachera – alergie ogólne
Zbadaj swoje reakcje alergiczne na różne czynniki środowiskowe. Test pozwala dokładnie określić przyczyny alergii i wspiera ich eliminację.
Więcej informacji
Test pasożyty
Kompleksowy test, który pomaga wykryć obecność pasożytów w ciele. Dzięki niemu możliwe jest skuteczne oczyszczenie organizmu i poprawa zdrowia.
Więcej informacji
Test wirusy
Pozwala wykryć różnorodne wirusy, które mogą obciążać organizm. To skuteczny sposób na diagnostykę infekcji i poprawę odporności.
Więcej informacji
Test grzyby i pleśnie
Zidentyfikuj obecność grzybów i pleśni, które mogą być przyczyną alergii, problemów skórnych czy przewlekłego zmęczenia. Test pozwala na wdrożenie skutecznej terapii.
Więcej informacji
Test bakterie
Ten test pozwala dokładnie zbadać obecność bakterii w organizmie. Dzięki analizie możemy określić, które z nich mogą wpływać negatywnie na Twoje zdrowie.
Więcej informacji
Test alergie – trawy i pyłki
Sprawdź swoją wrażliwość na alergeny, takie jak pyłki i trawy. Test pomoże Ci lepiej radzić sobie z sezonowymi alergiami.
Więcej informacji
Test organy
Analiza kondycji Twoich narządów wewnętrznych. Dzięki temu badaniu możesz szybko wykryć potencjalne problemy zdrowotne.
Więcej informacji
Test metale i metale ciężkie
Dowiedz się, czy w Twoim organizmie zalegają szkodliwe metale ciężkie. Wczesna diagnostyka pozwala na skuteczne usunięcie toksyn.
Więcej informacji
Test witaminy i aminokwasy
Sprawdź, czy Twojemu organizmowi nie brakuje kluczowych witamin i aminokwasów. Idealny dla osób dbających o zdrowie i odpowiednią suplementację.
Więcej informacji
Test wewnętrzne środowisko
Dowiedz się, jak wygląda ogólna równowaga wewnętrzna Twojego organizmu. To świetna metoda na ocenę stanu zdrowia i dobór indywidualnej terapii.
Więcej informacji
Terapia biorezonansowa
Indywidualnie dopasowana terapia biorezonansowa wspiera organizm w regeneracji, walce z infekcjami i eliminacji toksyn. Możesz wybrać sesje o różnej długości: 1, 2 lub 3 godziny.
Więcej informacji